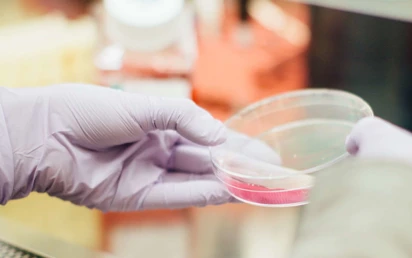
Travel Vaccination Service 2

Om
The Customer er en ledende leverandør av ferievaksiner med et mål om å fjerne stresset ved å få ferievaksiner. Med lisensierte klinikker over hele landet og tidsbestilling samme dag innen en time, kan du være ferieklar på mindre enn 24 timer.
The Customer er en ledende leverandør av ferievaksiner med et mål om å fjerne stresset ved å få ferievaksiner. Med lisensierte klinikker over hele landet og tidsbestilling samme dag innen en time, kan du være ferieklar på mindre enn 24 timer.

Kunden vår ønsket å forvandle visjonen sin til et moderne digitalt produkt. For å nå kundens forretningsmål delte vi opp prosjektgjennomføringen i to forskjellige digitale løsninger:
Etter en innledende diskusjon identifiserte vi følgende hovedkrav:
For nettstedet:
For det kliniske systemet:
For å lykkes med å implementere de nødvendige funksjonene og skape produktet, fulgte teamet vårt disse tekniske trinnene:
For det offentlige nettstedet:
For det kliniske systemet:

Vi har lykkes med å skape to sammenkoblede produkter: et offentlig nettsted og et klinisk system. Nettstedet tilbyr generell informasjon om vaksiner og vaksinasjoner, og hjelper brukerne med å bestille time på passende tidspunkter og steder.
Det kliniske systemet håndterer effektivt forespørsler fra brukere som ønsker vaksinasjonstjenester, for eksempel de som forbereder seg på internasjonale reiser. Systemet inneholder funksjoner for timeadministrasjon, lagerhåndtering og klinikerkonsultasjoner, noe som sikrer en smidig drift av klinikken.
Vår erfaring med å bygge applikasjoner for helsevesenet ved hjelp av .NET og Azure var avgjørende for prosjektets suksess. Kunden valgte UKAD på grunn av svært positive tilbakemeldinger fra en annen kunde i Storbritannia, og våre innledende tjenester innen forretningsanalyse og POC sørget for en godt planlagt og gjennomført utviklingsprosess.
I tillegg fortsetter vi å støtte applikasjonen med våre vedlikeholdstjenester, noe som gir stabilitet og kontinuerlig tilfredshet for kunden. UKADs omfattende løsning har ikke bare forbedret kundens driftseffektivitet, men også bidratt til potensielle partnerskap og langsiktig vekst.
UKAD tilbyr spesialiserte Azure-utviklings- og DevOps-konsulenttjenester som er utformet for å møte behovene til virksomheter som søker pålitelige skyløsninger. Som Gold Microsoft Partner med over 18 års erfaring tilbyr vi Azure-sertifiserte utviklere, skalerbar applikasjonsutvikling og omfattende datadrevne systemer som er skreddersydd til dine behov. Tjenestene våre omfatter Azure Cloud Consulting for å definere strategier, DevOps-implementering for kontinuerlig levering og automatisering, og hybride skyløsninger som integrerer lokale systemer med Azure-infrastruktur.

UKAD tilbyr eksperttjenester innen forretningsanalyse som hjelper deg med å ta informerte, strategiske beslutninger for å sikre prosjektets suksess. Ved å analysere kundeatferd, markedstrender og dine unike forretningsbehov gir vi deg datadrevet innsikt som former effektive løsninger. Vi gir deg den klarheten og retningen du trenger for å sikre at løsningene dine er i tråd med målene dine og driver langsiktig vekst. La oss veilede deg mot mer gjennomtenkte og effektive beslutninger.

La oss dra nytte av kraften til UKADs sertifiserte .NET-utviklere for å realisere prosjektet ditt. Med dyp ekspertise og dokumenterte sertifiseringer leverer teamet vårt sikre, skalerbare løsninger som er i tråd med dine forretningsmål. Enten det dreier seg om å bygge sky-apper eller komplekse bedriftssystemer, sørger vi for resultater av høy kvalitet som oppfyller de høyeste standardene, og hjelper deg med å oppnå suksess med presisjon og effektivitet.
